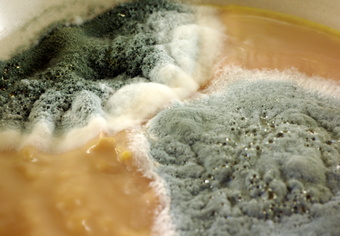

Navigation
Detail
Schimmelpilze, Schadschimmel
Urheber:
Holger Hunger, CC0
Bildnummer:
P9102
Auflösung:
3491x2421
Format:
PNG
Quelle:
https://www.schulportal-thueringen.de/pixiothek/detail?tspi=P9102
Kurzbeschreibung:
Das Foto zeigt Schimmelpilze auf verdorbenen Lebensmitteln. Das Bild ist unter CC0 lizenziert und kann somit frei verwendet werden.
Verwandte Bilder (Auswahl)

Schimmelpilze, Schadschimmel
(3872x2592)
Verwandte Medien (Auswahl)

Ernährung - Materialien fü...
(öffentlich) Bildung für n...
Online-Medium
(2012)

Ernährung - Materialien fü...
(öffentlich) Bildung für n...
Online-Medium
(2012)

Ernährungspyramide zum Bas...
(öffentlich)
Online-Medium
(2025)

Ernährungstypen
(öffentlich)
Online-Medium
(2024)

Europäische Gaumenfreuden
(öffentlich)
Online-Medium
(2013)

Experimento | 8+: C1 Nährstoffe
(öffentlich) Medienpaket...
Online-Medium
(2016)

Braucht der Mensch Fleisch?
(öffentlich) ZDF: Terra ...
Online-Medium
(2021)

Klar Soweit? No. 63 - Ganz s...
(öffentlich) Wissenschaf...
Online-Medium
(2019)

Klar Soweit? No.22 - Lost ...
(öffentlich) Wissenschaf...
Online-Medium
(2015)

So geht’s nachhaltig!
(öffentlich) Unterrichts...
Online-Medium
(2013)






